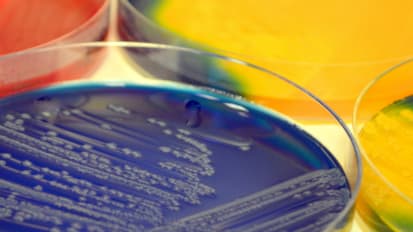

Clinical Research Advancements Articles
Articles
 News
News
New Center to Explore the Influence of Sex and Gender on Health Care
Gender-specific medicine considers how human biology differs between men and women and how the diagnosis and treatment of diseases may differ regarding both biological sex and gender-specific lived experience.
 News
News
Inflammatory Biomarker Associated with Mitochondrial Decline Further Linked to Frailty
Researchers at the Johns Hopkins University School of Medicine have developed a mouse model that successfully mimics the development of frailty as mammals — likely including people — get older.
 News
News
In an eight-year study of more than 600 community-dwelling older adults, Johns Hopkins Medicine researchers say they have further linked levels of cell-free DNA (DNA fragments resulting from cell death) circulating in the blood to chronic ...
 News
News
In two studies using nationally representative data from the National Health and Aging Trends Study gathered on thousands of Americans, researchers from the Johns Hopkins University School of Medicine and Bloomberg School of Public Health ...
 News
News
Research Focuses on Improving Care for People with Dementia
Adults with dementia are sometimes thought to be homogenous and presumed to use a lot of health care services, especially later in life, says geriatrician Stephanie Nothelle. But two recent studies Nothelle directed suggest that’s not the case.
 News
News
Johns Hopkins Research Suggests Ways to Improve the Medicare Annual Wellness Visit
A new study from Johns Hopkins researchers offers caution about the limitations of the Medicare Annual Wellness Visit, finding that up to 25% of older adults at risk for falls still were prescribed a medication that is considered high risk for that condition.
 News
News
An interview with Ami Shah, co-director of the Johns Hopkins Scleroderma Center
 News
News
Family Caregivers Share Both Positive And Challenging Experiences In New Study
An old adage goes something like this: “Growing old is not for the faint of heart.” Perhaps there’s something else about the aging human condition at parity with this wisdom: caregiving is both challenging and rewarding.
 News
News
Pulse Ox: Vital Tech with a Fatal Flaw
In the early days of the COVID-19 pandemic, Ashraf Fawzy remembers one patient who arrived in the intensive care unit of The Johns Hopkins Hospital, a Black woman with asthma.
 News
News
Blood Levels of ‘Free Range’ DNA May Signal Early Detection of Dementia and Frailty
In a long-term prospective study of more than 600 older participants, Johns Hopkins Medicine researchers say they have evidence that higher levels of cell-free DNA circulating in the blood may signal increased risk of chronic inflammation ...
 News
News
Understanding Patient Preferences for Deprescribing Medications
Geriatricians routinely see older adults who are prescribed an overload of medicines that may not benefit them or be aligned with their goals —and that often cause harm including falls, cognitive impairment, hospitalization and death. ...
 News
News
Sjögren’s Disease: Making the Correct Diagnosis
An Interview with Alan Baer, founding Director of the Jerome L. Greene Sjögren’s Center at Johns Hopkins.
 News
News
Advances in Precision Medicine for Scleroderma and Myositis
New Johns Hopkins research aims to better predict trajectories of disease and how patients will respond to treatments.
 News
News
Research Advancements Focus on Biomarkers, Disease Management, COVID-19 and More
Despite the challenges posed by the COVID-19 pandemic, 2020 was an exciting year for researchers in the Johns Hopkins Division of Nephrology. Here are some of the high impact journal articles published by the team’s researchers in 2020.
 News
News
Inclusion Body Myositis: Learning from Musician Peter Frampton
Frampton’s finger dexterity was not at all what his doctor, rheumatologist Lisa Christopher-Stine, M.D., Director of the Johns Hopkins Myositis Center, expected to find; then again, neither was Frampton himself.
 News
News
PTLD: Recent Advancements in Long-Haul Lyme Disease Research
Some people get bitten by a deer tick that’s infected with Borrelia burgdorferi, develop a rash, are diagnosed with Lyme disease, take antibiotics, feel better, and get their life back to normal. Others aren’t so lucky. Diagnosed just ...
 News
News
Racial/Ethnic Disparities in Care for Patients with Failing Kidneys Unchanged for Decade
A new study by Johns Hopkins Medicine, the Johns Hopkins Bloomberg School of Public Health, the Harvard Medical School and the Duke University School of Medicine shows that racial and ethnic disparities in the availability and quality ...
 News
News
For Blacks with Respiratory Ills, Individual and Neighborhood Poverty Yield Worse Outcomes
Socioeconomic status — for both individuals and the neighborhoods in which they live — can negatively impact the health outcomes for Blacks with chronic obstructive pulmonary disease and other respiratory illnesses.
 News
News
Molecularly Targeted Therapies for Salivary Gland Cancer
Experts at the Johns Hopkins Kimmel Cancer Center at Sibley Memorial Hospital use highly specialized hormone therapy to target salivary gland tumors based on genetic characteristics.
 News
News
When Statins Are Not an Option
Lowering Cholesterol Levels in Patients with Immune-Mediated Necrotizing Myopathy
 News
News
Autoantibodies Offer Clues to Co-Incidence of Cancer and Scleroderma in Some Patients
The Johns Hopkins Scleroderma Center followed a group of 168 patients with anti-RNA Pol III antibodies for five years, comparing those with and without detectable cancer.
 News
News
Rapid Response to Immune-Related Adverse Events Improves Patient Care
Published results of a Johns Hopkins pilot study showed 73.5% of physicians in the study said recommendations from an immune-related toxicity (IR-tox) team changed their diagnosis or management of immune-related adverse events.
 News
News
Favorable five-year survival rates from the first multidose clinical trial of the immunotherapy drug nivolumab (anti-PD-1) reported.
 News
News
Johns Hopkins pilot study showed a direct molecular Lyme disease diagnostic test could be used to identify and genotype Borrelia burgdorferi during antibiotic treatment in early Lyme disease patients.
 News
News
Turning Silenced Cancer Genes Back Into Fighters
Targeting protein known as UHRF1 may shrink tumors by restoring aberrant gene regulation in cancer cells.
 News
News
Study Shows Experimental Drug Can Encourage Bone Growth in Children with Dwarfism
New study results provide hope for altering bone growth in children and teens with a common form of dwarfism
 News
News
Out of Many Ovarian Precancerous Lesions, One Becomes Cancer
Some deadly ovarian cancers arise from lesions genetically unrelated to each other
 News
News
Precision Medicine Symposium Highlights a New Path for Data-Driven Research
A May 30 event will spotlight the current and future role of precision medicine at Johns Hopkins Medicine.
 News
News
Johns Hopkins Study Suggests Consistent Fasting Blood Glucose May Be As Important As A1C
A Johns Hopkins study suggests people whose blood sugar varies widely over time may be at increased risk for serious health problems.
 News
News
Deep Machine Learning Can More Accurately Identify Erythema Migrans Rashes in Early Lyme Disease
A new study from Johns Hopkins showed a deep machine learning approach can more accurately identify erythema migrans rashes in early Lyme disease. This could facilitate earlier and more accurate diagnoses, earlier and more effective treatments, ...
 News
News
Big Data Helps Shape A New Model for Live Kidney Donation
A tool developed by Morgan Grams, MD, PhD, screens potential kidney donor candidates by estimating their own chance of developing kidney disease, and it has been widely adopted by renal specialists around the globe.
 News
News
Optimizing Outcomes for Type 2 Diabetes with Research and Education
News & Publications January 9, 2019
 News
News
PET Imaging of Glial Activation in Patients with Post Treatment Lyme Disease
This study uses a neuroimaging radiotracer with positron emission tomography (PET) to quantify cerebral glial activation in brains of patients with post-treatment Lyme disease. Results show elevated central nervous system immune activation ...
 News
News
Cancer Patients Blindsided by Treatment-Induced Inflammatory Arthritis
News Release December 13, 2018
 News
News
News & Publications November 26, 2018
 News
News
Preventing Neonatal Infection: Researchers Improve Long-Term Outcomes for Preemies
Infection prevention efforts are paramount in hospitals, especially in neonatal intensive care units.
News
News
New Directions in Preventing Neonatal Dysbiosis
Necrotizing enterocolitis is one of the leading causes of death in infants.
 News
News
Spread of Deadly Eye Cancer Halted in Cells and Animals
News and Publications November 12, 2018
 News
News
Hopkins Model for Glucose Management Reduces Complications, Improves Patient Outcomes
An observation that cardiac surgery patients at The Johns Hopkins Hospital who had diabetes appeared to have longer lengths of stay launched the Inpatient Diabetes Management Service.
 News
News
Gender Differences in Psoriatic Arthritis
In a recent study, Johns Hopkins researchers and colleagues show that women patients with psoriatic arthritis have worse patient-reported outcomes.
 News
News
Improving Outcomes for Critically Ill Patients
Dale Needham and colleagues investigate a novel combination of exercise and protein supplementation for patients early during ICU treatment.
 News
News
A Multidisciplinary Team Takes On Nontuberculous Myobacterial Lung Disease
Nontuberculous mycobacteria, or NTM, is now the dominant mycobacterial disease in the U.S., although the infections are not generally thought to pass from person to person. Image shows 3D rendering of NTM.
 News
News
Johns Hopkins Kimmel Cancer Center Researchers Using Big Data to Predict Immunotherapy Responses
Cancer researchers are discovering new ways to monitor the effectiveness of immunotherapy treatments
 News
News
Turning Off Protein Could Boost Immunotherapy Effectiveness on Cancer Tumors
News & Publications - July 31, 2018
 News
News
The (Remote) Eye Doctor Will See You Now
The ophthalmology telemedicine program is saving patients considerable time and stress.
 News
News
Three Approaches to Precision Medicine for Improved Patient Care
INSIGHT November/December 2017
 News
News
Artifact App Improves Accuracy of Patient Data in Medical Records
The app is available on mobile, tablet or desktop, so providers can answer questions on the go.
 News
News
Life and Death: Hopkins Team Finds Hospital Readmissions Sometimes Save Lives
Safety Insider September 1, 2016
Specialty Channels
- Clinical Research Advancements
- Dermatology
- Gastroenterology
- Geriatric Medicine and Gerontology
- Gynecology and Obstetrics
- Heart and Vascular
- Neurology and Neurosurgery
- Oncology
- Ophthalmology
- Orthopaedics
- Otolaryngology—Head and Neck Surgery
- Patient Safety
- Pediatrics
- Pediatric Diabetes and Endocrinology




























